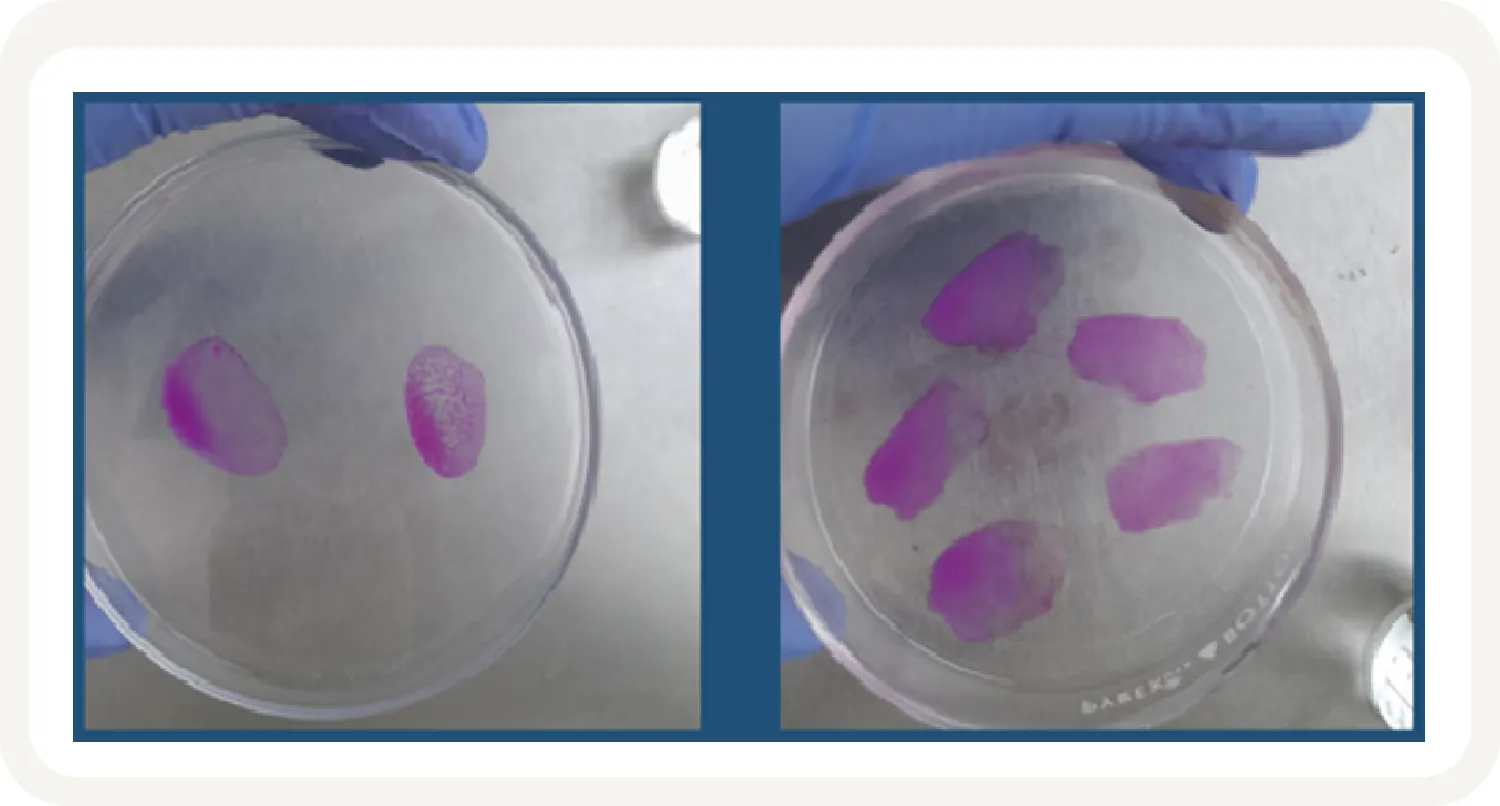

Luis Daniel Nacionalidad:
Grado académico:
Antonio
Jorge Luis
Luis Antonio
Marco Antonio
Víctor Hugo 2992-7293
La porcicultura es una de las líneas de producción del sector agropecuario con beneficios económico y social, ya que la crianza y la comercialización de los cerdos (Sus scrofa domestica) genera empleos y urbaniza las zonas donde se realiza. En México existen tres sistemas de producción de carne de cerdo: el tecnificado, semi-tecnificado y de traspatio (www.gob.mx/agricultura).
El cerdo de traspatio o de subsistencia constituye un sistema de producción y comercialización doméstico, caracterizado por la engorda de pocos animales, que contribuye a la economía familiar y al consumo local de proteína animal; en general, esto ocurre en comunidades rurales. Las instalaciones de la crianza de traspatio son rústicas, localizadas cerca de la casa-habitación y la fuerza de trabajo es familiar. La alimentación de los cerdos se asocia a desperdicios alimenticios o en su defecto, se permite que los animales deambulen libremente para que ellos consigan su propio alimento; repercutiendo, por un lado, a una inversión económica baja para la crianza y por otro, exponiendo a los animales a agentes infecciosos. Entre las patologías más reconocidas en la críanza de cerdos de traspatio destacan las helmintiosis ocasiondas por Taenia solium, Ascaris suum, Trichuris suis y Trichinella spiralis (Pulido- Villamarín et al. 2019; Gómez-Mendieta et al. 2024).
La producción en los sistemas tecnificados, se caracteriza por las medidas sanitarias instrumentadas y porque cuentan con instalaciones apropiadas para reproducción y los animales consumen alimento balanceado. Estos animales generalmente son destinados para su faenado a un rastro inspeccionado o pueden ser vendidos como pie de cría a otras granjas (Estrada-Salmerón et al., 2001). Sin embargo, en algunas ocasiones, puede haber fallas en la bioseguridad y es cuando se presentan brotes de enfermedades infecciosas; entre las más comunes se encuetran las ocasionadas por el virus respiratorio reproductivo del cerdo o PRSS, el virus de la diarrea epidémica porcina, las infecciones por Salmonella, Leptospira, Erisipela y algunas veces Brucella. Las enfermedades parasitarias son raras en la porcicultura tecnificada, pero se llegan a presentar casos de cisticercosis (Taenia solium).
La implementación de medidas de seguridad alimentaria y la búsqueda de patógenos en productos de origen animal son una constante porque algunas de las enfermedades son de potencial zoonótico, es decir, tienen capacidad de transmitirse del cerdo al ser humano y viceversa (Pozio, 2000; Guzmán-Hernández et al., 2016). En la actualidad hay varios métodos diagnósticos para la vigilancia epidemiológica de la prevalencia de estas parasitosis, la mayoría de los cuales están asociados a la determinación de anticuerpos que proporcionarían la información necesaria para establecer la circulación del patógeno en una región en particular (Dacal et al., 2020; Sadaow, et al., 2018).
El estudio de la prevalencia de las enfermedades infecciosas y parasitarias está relacionado con el desarrollo económico-social además de, influir en los programas de salud pública, veterinaria y silvestre. En el caso de la salud animal, las enfermedades infecciosas y parasitarias limitan la producción de cerdos, así como pueden causar la muerte, la eutanasia prematura o el decomiso de las canales repercutiendo en la economía de los productores (Kipper et al., 2011; Taylor et al., 2007).
En varios países, el control sanitario en cerdos domésticos se lleva a cabo mediante la búsqueda de anticuerpos contra Taenia solium (prevalencia de 11.2 a 40.5%) y contra Trichinella spiralis (prevalencia de 0 a 4.5%) (Addo et al., 2021; Pinilla, et al. 2021; Söderberg et al. 2021). Incluso, en México, se ha buscado la presencia de anticuerpos contra Trichinella (prevalencia 5.5%) en jabalies silvestres confinados a unidades de manejo animal (de-la-Rosa-Arana et al., 2021).
En México, los estudios sobre la prevalencia de enfermedades infecciosas y parasitarias en animales destinado al consumo huamano, son insuficientes y, particularmente, para Brucella en porcinos, no hay un programa de vigilancia epizootiológica (SAGARPA, 1996), pero existe un estudio en cerdos de traspatio donde ninguno de 1,091 animales fue positivo (Favila-Humara et al., 2017). En general, hacer estudios sistemáticos sobre la prevalencia de agentes infecciosos en México, resulta complicado por varias razones; una de ellas asociada a que la industria porcicola tiene un inventario fluctuante mayor a los 18 millones de cabezas por año (SENASICA, 2021) y, por otro lado, no hay un estimado certero del inventario de cabezas de traspatio, sin tomar en cuenta que existen poblaciones con número indeterminado de cerdos de “vida libre”, denomidados “cerdos alzados” o “asilvestrados”. Este trabajo tuvo el objetivo de identificar la frecuencia de anticuerpos contra Trichinella, Taenia y Brucella en porcinos criados en sistema de traspatio y en rancho tecnificado de distintas localidades de México para actualizar la situación epidemiológica de estos agentes etiológicos con potencial zoonótico.
Un total de 362 muestras séricas de porcinos de traspatio se obtuvieron por donación (figura 1). Se obtuvieron 144 muestras del Estado de Querétaro por conducto del Programa para la Vigilancia Epidemiológica de la Fiebre Porcina Clásica, Secretaria de Agricultura y Desarrollo Rural; además, se obtuvieron muestras de los Estados de Morelos (n=73), Sinaloa (n=68) y Durango (n=70) por conducto del InDRE, Secretaría de Salud. Todas las muestras se obtuvieron mediante un muestreo no probabilístico por conveniencia. Simultáneamente se obtuvieron por donación de una granja técnificada del Estado de Querétaro 190 muestras séricas porcinas de hembras gestantes mayores a tres meses de edad y gestantes. Con la intensión de determinar si el número de muestras obtenidas por Estado tendría alguna significancia estadística, se infirió que las 18 millones de cabezas porcinas se distribuyen homogéna, por lo que cada Estado tendría un inventario de medio millón de cabezas. Suponiendo una prevalencia del 10% para los agentes etiológicos aquí estudiados y un intervalo de confianza del 95%, el tamaño de muestra sería de 139; para un intervalo del 90% sería de 98 muestras y, de 60 para 80% (www.OpenEpi.com). Las muestras de sangre, en cantidad de 3 a 5 mL, fueron trasladadas al laboratorio en cadena fría a 4°C para separar el suero por centrifugación a 3,500 rpm durante cinco minutos. Posteriormente fueron almacenadas a -20°C hasta su uso.

Figura 1. Cerdos de traspatio. La fotografía fue tomada previamente a la toma de muestras y donada para este estudio por un investigador del InDRE.
Se obtuvieron 3 tipos diferentes de antígenos. Para la determinación de anticuerpos contra T. spiralis se prepararon los productos de excreción y secreción de la larva muscular (Gómez-Mendieta et al., 2024) y se utizaron en un ensayo inmunoenzimático (ELISA). Para la determinación de anticuerpos contra el cisticerco de Taenia solium se empleó una estrategia donde los sueros se evaluaron por ELISA empleando el fluido vesicular de T. crassiceps (Hernández et al. 2019). La determinación de anticuerpos contra Brucella (figura 2) se llevó a cabo con la prueba de tarjeta o Rosa de Bengala usando el antígeno de B. abortus cepa 1119-3 a una concentración de 8% (Aba test, Productora Nacional de Biológicos Veterinarios. Ciudad de México, México).

Figura 2. Evaluación con la prueba de tarjeta para el diagnóstico de Brucella. La fotografía fue tomada durante el entrenamiento para este estudio. Se muestra en la primera fila 5 sueros evaluados, la rección de aglutinación se observa en la tercera posición de la tarjeta.
Los resultados fueron analizados como frecuencia simple y se empleó la prueba de Z para comparar los resultados obtenidos entre los sistemas de producción. Los calculos se realizaron con el software Ope-Epi para estadísticas epidemiológicas de código abierto para Salud Pública (www.OpenEpi.com).
La tabla 1 muestra los resultados obtenidos para la determinación de anticuerpos contra los agentes etiológicos aquí estudiados. Para Trichinella se encontraron 9 muestras positivas en los sueros de traspatio; 5 muestras fueron de Sinaloa (n=5) y 4 de Morelos. La figura 3 muestra los resultados de densidad óptica obtenidos en el ELISA. No se obtuvieron muestras positivas en los sueros de granja tecnificada. Para el cisticerco de Taenia solium se encontraron 6 muestras positivas en los sueros de traspatio (figura 4); las 6 muestras fueron de Durango (n=6); no se encontraron sueros positivos en la granja tecnificada. En la prueba de rosa de Bengala para el diagnóstico de Brucelosis, ninguna muestra (traspatio y técnificado) fue positiva (figura 5).


Figura 3. Reactividad por ELISA de las muestras séricas porcinas contra los antígenos de la larva muscular de Trichinella spiralis. Se observa la reactividad de las muestras de traspatio de los Estados de Sinaloa (SIN), Querétaro (QRO), Morelos (MOR), Durango (DUR) y la reactividad de las muestras de la granja tecnificada (QRO-GT). El punto de corte es la línea horizontal roja.

Figura 4. Reactividad por ELISA de las muestras séricas porcinas contra el fluido vesicular de Taenia crassiceps. Se observa la reactividad de las muestras de traspatio de los Estados de Sinaloa (SIN), Querétaro (QRO), Morelos (MOR), Durango (DUR) y la reactividad de las muestras de la granja tecnificada (QRO-GT). El punto de corte es la línea horizontal roja.
Figura 5. Diagnóstico para Brucella en muestras séricas porcinas. En panel izquierdo se muestran, testigo negativo y testigo positivo (+), respectivamente, de izquierda a derecha. En el panel derecho se observan, de manera representativa muestras de porcino de traspatio y de granja.
La tabla 2 resume la frecuencia global de los agentes infecciosos evaluados y las técnicas diagnósticas, tanto para el sistema de traspatio como para el tecnificado. La frecuencia globlal en traspartio fue del 2.2% para Trichinella, mientras que para Taenia fue de 1.7%. No hubo muestras positivas para el sistema tecnificado ni para Brucella.
Las figuras 6, 7 y 8 muestran mapas epizootiológicos porcino de la distribución de Taenia, Trichinella y Brucella respectivamente. El mapa de Taenia se construyó de novo, mientras que el mapa de Trichinella tomo como base el trabajo de Guerrero-Medina (2022), que reporta datos provenientes de cerdos faenados en rastros de distintos estados del país (color verde y azul); este mapa lo complementamos con los hallazgos de anticuerpos contra T. spiralis en los estados de Sinaloa y Morelos (color rosa y amarillo respectivamente). El mapa para Brucella tomó como base los datos de Favila-Humara (2017) en el sureste de México, donde 70.46% de las unidades porcinas incluidas en el muestreo, fueron granjas de traspatio.
Tabla 2. Frecuencia global de seroprevalencia para Brucella, Taenia y Trichinella


Figura 6. Mapa epidemiológico de la distribución de Taenia solium en cerdos. Los estados en colores representan las localidades muestreadas del presente estudio, Sinaloa (azul), Durango (naranja), Querétaro (morado), Morelos (verde). Los estados en color rosa indican que hay estudios que han evaluado prevalencia de cisticercosis porcina previamente (Estado de México, Morelos, Guerrero, Puebla, Oaxaca, Chiapas, Tabasco, Campeche, Yucatán y Quintana Roo).

Figura 7. Mapa epidemiológico de la distribución de Trichinella en cerdos. En color verde están representados los estados en los que se han realizados estudios para la detección de T. spiralis utilizando pruebas diagnósticas directas (triquinoscopía y digestión artificial), mientras que en azul los que se usaron pruebas indirectas (ELISA). Las prevalencias de los estados son, Zacatecas (1) 30%, el Estado de México (2) métodos directos 0-6% y métodos indirectos 12.4%, Jalisco (3) 0.32-4.2%, Puebla (4) 3.3%, Ciudad de México (5) 0.001-1.05 %, Sonora (6) 0.1% y Oaxaca (7) con 0.9 % (Guerrero-Medina, 2022). Los datos de Sinaloa 1.1% y Morelos 1.3% (rosa y amarillo respectivamente) son contribución de este trabajo.

Figura 8. Mapa epidemiológico que muestra la ausencia de anticuerpos contra Brucella en cerdos. En gris los Estados de Veracruz, Oaxaca, Chiapas, Tabasco, Campeche, Yucatán y Quintana Roo, (Favila-Humara, et al. 2017). Los Estados de Sinaloa (azul), Durango (naranja), Querétaro (morado) y Morelos (verde) corresponden a los resultados del este estudio.
En México, los estudios sobre la prevalencia de enfermedades parasitarias e infecciosas con potencial zoonótico en animales destinados al consumo humano, son insuficientes; por lo que en este trabajo se buscaron anticuerpos específicos contra Trichinella, Taenia y Brucella en porcinos criados en sistema de traspatio y en rancho tecnificado de distintas localidades de México. Nuestros hallazgos mostraron que la frecuencia global para Trichinella fue de 2.2%, y para Taenia fue de 1.7% en la crianza de traspatio, mientras que no hubo muestras positivas para Brucella en ninguno de los sistemas. Estos datos confirman que la seroprevalencia de agentes infecciosos en cerdos de sistemas de producción tecnificada es menor con respecto a los cerdos de traspatio.
En el sistema de traspatio hay mayor probabilidad de encontrar cerdos portadores de agentes etiológicos con potencial zoonótico debido a las deficientes condiciones zoosanitarias que podrían facilitar la transmisión intra e interespecie (Favila Humara et al. 2017) y también, debido a que estos animales deambulan libremente puede ser el punto de contacto de los cerdos con animales de vida silvestre y a su vez la transmisión de las zoonosis. Además, estos datos indican que en el sistema tecnificado cuenta con las condiciones normativas zoosanitarias para garantizar la calidad y seguridad de los productos porcinos.
Es importante llevar la información de estos estudios a las localidades donde existe la crianza de cerdos en traspatio para reforzar las acciones de prevención y control como mantener el ambiente de crianza en condiciones higiénico-sanitarias apropiadas, adecuada alimentación y evitar que estén en contacto con la basura, letrinas, heces humanas, e ingieran desperdicios. Así mismo, es importante combatir la presencia de roedores, ya que son posibles portadores y transmisores de estas enfermedades.
Existen trabajos previos que se han realizado en algunos países, para el control sanitario en cerdos domésticos, donde se lleva a cabo la búsqueda de anticuerpos. En Ghana, ejemplo, se ha documentado una seroprevalencia del 24.9% para Taenia solium (prevalencia desde 11.2 al 40.5%) y, 4.5% para Trichinella spiralis (prevalencia desde 0 a 4.5%) (Addo et al., 2021). En Bucaramanga, Colombia no se detectó la infección contra T. spiralis en 200 sueros porcinos analizados por ELISA; sin embargo, se registró una seroprevalencia del 40.5% para cisticercosis porcina por T. solium (Pinilla, et al. 2021). Por otra parte, en Camboya se obtuvieron y evaluaron por medio de ELISA, 242 muestras de sueros porcinos para determinar la seroprevalencia de cisticercosis porcina y Trichinella spp. en pueblos rurales. Los resultados indicaron prevalencia de 11.2% para Taenia spp. y 2.5% para Trichinella spp. (Söderberg et al. 2021). De manera particular en México, los datos para Brucella en cerdos es insuficiente, aunque se ha declarado que nuestro país está libre de esta bacteria en cerdos, pero es importante llevar a cabo estudios epidemiológicos para corroborar ese estatus epidemiológico. Por lo tanto, este es el primer trabajo que busca mostrar cuál es el panorama epidemiológico de la Brucella en cerdos en la última década.
Como perspectivas que se tienen es llevar el estudio de estas enfermedades zoonóticas a otras partes u otros estados productores de carne porcina de nuestro país para hacer más muestreos y tener mayor conocimiento de la situación epidemiológica de estas zoonosis en todo el territorio o la mayor parte, así como aplicar o reforzar las medidas de control y prevención donde sea necesario. Esto tendría distintos beneficios, ya que si conseguimos tener carne libre de patógenos lograríamos un comercio más justo, carne de calidad para mexicanos y para su exportación, lo cual se traduce en mayores ganancias para los productores. Además, otro beneficio no menos importante sería lograr la erradicación de la cisticercosis, ya que nos encontramos ante la certificación de la ausencia de transmisión de Taenia y la falta de datos sistemáticos en nuestro país de Trichinella.
Nuestros resultados indican una frecuencia global de 1.7% para T. solium y 2.2% para T. spiralis, mientras que no obtuvimos muestras positivas para Brucella. En cuanto al sistema tecnificado no se registraron muestras positivas para ninguno de los agentes etiológicos evaluados. Los datos aquí reportados sugieren la disminución en la transmisión de los agentes etiológicos.
Programa para la Vigilancia Epidemiológica de la Fiebre Porcina Clásica, Secretaría de Agricultura y Desarrollo Rural e Instituo de Diagnóstico y Referencia Epidemiológicos, Secretaría de Salud por la donación de muestras. Luis Daniel Valencia Saavedra fué becario del CONAHCYT para estudios de maestría en el Programa de Salud y Producción Animal de FESC, UNAM. Luis Parra Oaxaca (FESC, UNAM) por su apoyo técnico. Eduardo Jiménez (Brucelosis, InDRE, SS) por el entrenaminto para ejecutar la prueba Rosa de Bengala. Víctor Hugo del Río Araiza, Marco Antonio Muñoz Guzmán y Jorge Luis de la Rosa Arana son becarios del Sistema Nacional de Investigadores del CONAHCYT, México.
1. www.gob.mx/agricultura/prensa/mexico-entre-los-principales-productores-y-consumidores-de-carne-de-cerdo-en-america-latina-y-el-mundo
2. Pulido-Villamarín A, Castañeda-Salazar R., Márquez-Hernández A, Martínez-Rodríguez J, Martínez-Triana D, Palencia-Sánchez F. 2022. Factores de riesgo asociados a las enfermedades zoonóticas derivadas de la producción porcícola: Una revisión exploratoria. Revista de Investigaciones Veterinarias del Perú. 33 (2): e22591. DOI: 10.15381/rivep.v33i2.22591
3. Mendoza-Gómez MF, Pulido-Villamarín A, Barbosa-Buitrago A, Aranda-Silva M. 2015. Presence of gastrointestinal parasites in swine and human of four swine production farms in Cundinamarca- Colombia. Rev MVZ Córdoba 20: 5013-5026.
4. Fávila-Humara, L.C., Palomares Reséndiz, E.G., Martínez Lara, A.C., Diosdado Vargas, F., Díaz Aparicio E. 2017. Porcicultura del sureste mexicano seronegativa a brucelosis. Quehacer científico en Chiapas.
5. Addo HO, Majekodunmi AO, Sampane-Donkor E, Ofosu-Appiah LH, Opare D, Owusu-Okyere G, Amegah KE, Bimi L. (2021). Seroprevalence of Taenia solium and Trichinella spiralis among Humans and Pigs in Ghana. Biomed Research Int. 2021-1031965. DOI: 10.1155/2021/1031965
6. Pinilla, J.C., Morales, E., Flores Muñoz, A. A. 2021. A survey for potentially zoonotic parasites in backyard pigs in the Bucaramanga metropolitan area, Northeast Colombia. Veterinary world. 14(2): 372-379.
7. de-la-Rosa-Arana JL, Ponce JB, Reyes NE, Vega V, Zepeda AP, Martínez VP, Gómez FR. (2021). Helminths of the wild boar (Sus scrofa) from units of conservation management and sustainable use of wildlife installed in the eastern economic region of Mexico. Animals. 11, 98.
8. Gómez-Mendieta LA, Bastida-Almaraz FJ, Salas-Ramírez M, Jasso-Villazul CE, Fuentes-Cervantes G, Gómez-De-Anda FR, Zepeda-Velázquez AP, Ponce-Noguez JB, de-la-Rosa-Arana JL. Serology survey of Ascaris suum and Trichinella spiralis in rural pigs in Southwestern Mexico. Vet Med Sci. 2024 Jul;10(4):e1474. DOI: 10.1002/vms3.1474.
9. SENASICA (2021). Estudio para determinar el impacto económico de la PPC en México. Secretaria de Agricultura y Desarrollo Rural. México https://dj.senasica.gob.mx/Contenido/files/2021/enero/An%C3%A1lsisSocioecon%C3%B3micoFPC_876a8d25-0d1b-4fa8-94e4-18d59e932257.pdf
10. Hernández M, Astudillo OG, Diego G, de-la-Rosa-Arana JL, Meza-Lucas A, García-Rodea R, Romo ML, Toledo A, Parkhouse RM, Garate T, Sciutto E, Fleury A. Immunodiagnosis of human neurocysticercosis: comparative performance of serum diagnostic tests in Mexico. Parasitol Res. 2019 Oct;118(10):2891-2899. DOI: 10.1007/s00436-019-06425-4
11. Guerrero Medina, L. J. 2022. Actualización epidemiológica de la infección por Trichinella en México. Tesis de licenciatura. Facultad de Estudios Superiores Iztacala, UNAM.
12. Söderberg R, Lindahl JF, Henriksson E, Kroesna K, Ly S, Sear B, Unger F, Tum S, Nguyen-Viet H, Ström Hallenberg G. Low Prevalence of Cysticercosis and Trichinella Infection in Pigs in Rural Cambodia. Trop Med Infect Dis. 2021 Jun
11;6(2):100. doi: 10.3390/tropicalmed6020100. PMID: 34207978; PMCID: PMC8293377.
13. www.OpenEpi.com
14. Kipper M, Andretta I, Gonzalez MS, Lovatto PA. (2011). Meta-analysis of the effects of endoparasites on pig performance. Veterinary Parasitology 181, 316-320.
15. Dacal E, Köster PC, Carmena D. (2020). Diagnóstico molecular de parasitosis intestinales. Enferm Infecc Microbiol Clin.; 38(Supl 1):24-31.
16. Sadaow L, Sanpool O, Phosuk I, Rodpai R, Thanchomnang T, Wijit A, Anamnart W, Laymanivong S, Win Pa Pa Aung JP, Maleewong W & Intapan PM (2018). Molecular identification of Ascaris lumbricoides and Ascaris suum recovered from humans and pigs in Thailand, Lao PDR, and Myanmar. Parasitology Research. 117: 2427–2436.
17. Pozio E. (2000). Factors affecting the flor among domestic, synanthropic and sylvatic cycles of Trichinella. Veterinary Parasitology. 93: 241- 262.
18. Guzmán H.R.L, Contreras RA, Ávila CED, y Morales GMR. (2016). Brucelosis: Zoonosis de importancia en México. Revista Chilena de Infectología; 33 (6): 656-662.